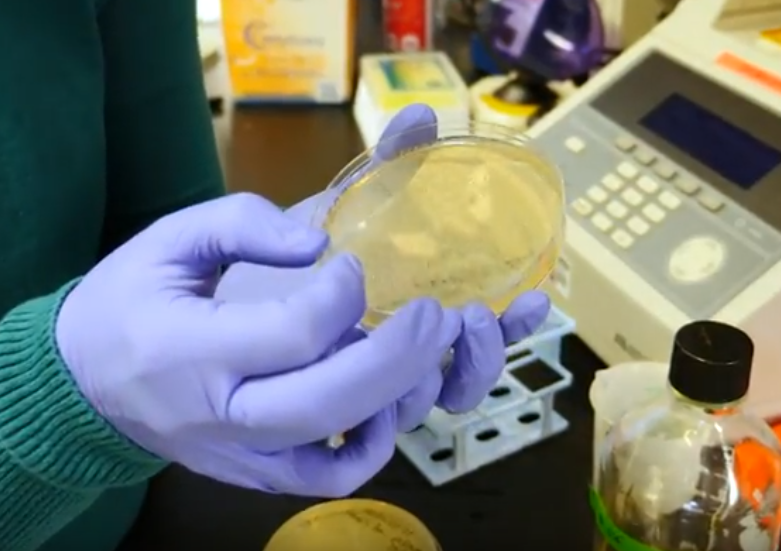
caption: Testing capacity for novel coronavirus in Washington increased significantly on Tuesday once a University of Washington virology lab began accepting samples.

Tom Banse
Regional Correspondent
About
Tom Banse covers national news, business, science, public policy, Olympic sports, and human interest stories across Washington state. Now semi-retired, Banse is an Olympia-based reporter with more than three decades of experience covering the Pacific Northwest. Most of his career was spent with public radio's Northwest News Network, but now in semi-retirement his work appears on multiple nonprofit news outlets including KUOW. His recent areas of focus range from transportation, U.S.-Canada borderlands, the Northwest region's planned hydrogen hub, and emergency preparedness.
Previously, Tom covered state government and the Washington Legislature for 12 years. He got his start in radio at WCAL-FM, a public station in southern Minnesota. Reared in Seattle, Tom graduated from Carleton College in Northfield, Minnesota with a degree in American Studies.
Location: Olympia
Languages: English, German
Stories
-

Newly jobless wait, some anxiously, for overloaded unemployment systems to catch up
The unemployment rolls in Washington state and Oregon continue to swell like never before. Washington's Employment Security Department said Thursday that close to half a million workers have applied for jobless benefits over the past three weeks. Oregon recorded just shy of 270,000 new claims in the same period, which is far more than the 147,800 net job losses in Oregon over the whole duration of the Great Recession.
-

Washington's COVID-19 hospital czar is cautiously optimistic
Washington's COVID-19 czar retired Navy Vice Admiral Raquel C. Bono is cautiously optimistic about the situation in the state.
-

There's still a 2020 census. Pandemic necessitates creativity in state promotion
Give yourself a pat on the back if you have already responded to the 2020 census. Residents of Pacific Northwest states are doing an above average job fulfilling their civic duty. But there is still a long way to go amid a virus pandemic that has forced many adjustments.
-

Washington, Oregon see unprecedented surge in unemployment claims
Mirroring the national trend, Washington and Oregon are experiencing an unprecedented spike in unemployment claims caused by the COVID-19 pandemic. In...
-

No shelter-in-place order imminent in Washington, but more restrictions likely in future
Washington Gov. Jay Inslee is not on the verge of issuing a statewide shelter-in-place order, as governors in California and elsewhere have done recently, a top Inslee aide said Friday.
-

No shelter-in-place order imminent in Washington, but more restrictions likely in future
Washington Gov. Jay Inslee is not on the verge of issuing a statewide shelter-in-place order, as governors in California and elsewhere have done...
-

Coronavirus makes lines at DMV anathema with Real ID deadline fast approaching
Thanks to coronavirus, one dreaded chore is temporarily off limits. No need to brace for long lines at the DMV to renew a driver license because those...
-

Boeing asked Washington state lawmakers to raise its taxes. They did.
-

Coronavirus testing restrictions frustrate Seattle area residents, criteria expected to broaden
As the death toll from the novel coronavirus continues to rise, many people who feel sick are naturally concerned they might have the infection. Until now, a coronavirus test has been difficult to get locally because of limited capacity and strict rules for who qualifies. However, both of those restrictions may relax soon.
-
Restrictive coronavirus testing criteria to be relaxed amid widening Washington outbreak
As the death toll from the novel coronavirus continues to rise, many people who feel sick are naturally concerned they might have the infection. Until...